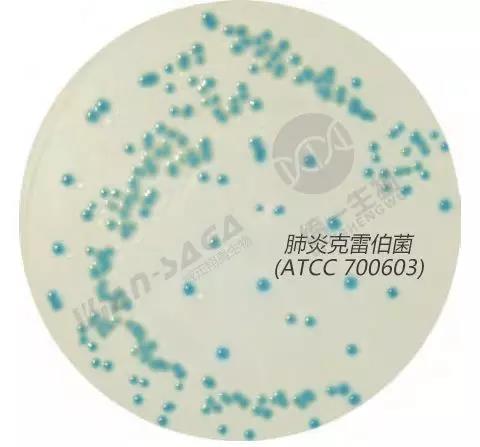
进口到货通知！微生物检测、叶酸检测等大批到货啦！

北京缔一生物科技有限公司品牌商
9 年
手机商铺
- NaN
- 0
- 0
- 1
- 0
推荐产品
公司新闻/正文
进口到货通知!微生物检测、叶酸检测等大批到货啦!
203 人阅读发布时间:2018-07-25 15:24
2018年7月第二周,又有一大批进口HiMedia维生素检测、微生物培养和检测、细胞活力检测产品,到货啦!
东西真不少,看看有哪些你会用得到?

这三瓶是Himedia
叶酸、烟酸和泛酸测定用培养基,
包装规格:100g/瓶,
储存温度:8°C以下密闭保存,
常用于食品厂和奶制品厂对以上维生素的测定。
在食品《国标》中,微生物培养法是第一选择方法,
它灵敏度高,重复性好,
为了避免本底过高和标曲偏移,一定要选择进口品牌哦。

这三瓶,是耐药菌分离检测的显色培养基,旁边是它们配套的添加剂,
①针对碳青霉烯耐药菌(ESBL)
货号:M1829-100G、M1829-500G、
包装规格:100g/瓶、500g/瓶
储存温度:2-8°C保存
碳青霉烯耐药菌显色培养基
②针对耐万古霉素肠球菌(VRE)
货号:M1830-100G、M1830-500G
包装规格:100g/瓶、500g/瓶
储存温度:2-8°C保存
③针对耐甲氧西林金葡菌
货号:MV1674-100G、MV1674-500G
包装规格:100g/瓶、500g/瓶
储存温度:2-8°C保存
用于临床检验科和微生物耐药相关的实验室。

这个装在袋子里,包裹得严严实实的产品,是不动杆菌的鉴定试剂盒
内含24种生化检查。

有些不动杆菌是医院内的超级耐药菌,快快把它揪出来吧。
货号:KB014-5KT
包装规格:5次/盒

这两种是HiTouch™柔软平板——即用型培养基,
即便遇到不规则的待检表面,也一样可以顺利接触取样!

底部有栅格,检测和计数,都很方便。
左边这款是HiTouch™酵母和霉菌计数平板,
货号:FL006
包装规格:50块/包
储存温度:2-8°C保存
适合食品厂、禽肉厂、化妆品厂、药厂
和医院对空气和物体表面的真菌检查。
右边是HiTouch™ 沙门氏菌计数平板,
货号:FL023
包装规格:50块/包
储存温度:2-8°C保存
可对食品、奶制品和药厂的原料成品,
进行沙门氏菌的分离计数。

快看看HiDtect™肠球菌快速鉴定纸,
它可快速鉴定来自食物、奶制品、水和药品中的肠球菌。
还有HiDtect™环境细菌鉴定纸,
它可用于食品厂和医院的环境检查。
它们盖在平板的菌落上1分钟,就可实现菌落的转印。
1-4小时后就可知道上面是什么菌落了。


这是DNA存储卡。
只要把要提核酸的样品,滴到这张小纸片上,
样品的DNA就可以轻松即时保存,方便运输和归档,
不但简化了DNA抽提,后期剪下一小片,
还可以做PCR检测呢!好方便!
货号:MBT109-100NO
包装规格:100张/盒
储存温度:15-30°C

这2个漂亮的盒子,分别是
MTT法细胞活力检测试剂盒(左),
货号:CCK003-1000
规格:1000次/盒
储存温度:室温保存
细胞ATP检测试剂盒(右),
货号:CCK051-1000
规格:1000次/盒
储存温度:-20°C避光
它们用于检测细胞的存活和增殖,以及药物对细胞毒性影响。
你的细胞健康吗?用它们可以做出准确的评价,
它们在新的肿瘤学、发育学、细胞生物学和研究组织再生的实验室都是必备神器呢!







